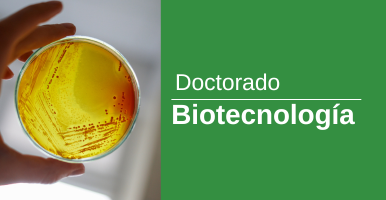

Z7_NQ5E12C0L86B60Q6EJJNRBIUH4
Portal U de A - Cabezote - WCV(JSR 286)
Z7_NQ5E12C0L86B60Q6EJJNRBIUH5
Signpost
Institutos
Z7_NQ5E12C0L86B60Q6EJJNRBIBS5
Portal U de A - Visor de Contenido - WCV(JSR 286)
Z7_NQ5E12C0L86B60Q6EJJNRBIBS7
Portal U de A - Visor de Contenido - WCV(JSR 286)
Z7_NQ5E12C0L86B60Q6EJJNRBIU96
UdeA - Información Menú - WCV(JSR 286)
Oferta
Pregrado |
||
![]() |
|
Titulo que otorga: Biólogo
Código SNIES: 452 Duración / Semestres: 10 Modalidad: Presencial Ciudad: Medellín, Carmen de Viboral, Andes, Caucasia, Yarumal Total créditos académicos: 167 Acreditación de Alta Calidad: Resolución 2204 del 30 de marzo del 2010, por un período de 7 años - MEN (en trámite de renovación). +Ver más |
Posgrados |
||
![]() |
Título que otorga: Magíster en Biología
Código SNIES: 516 Número total de créditos: 60 Duración: 4 semestres Metodología: Maestría (profundización e investigación)
Modalidad: Presencial, mediado por TICs.
Horario: Definido de acuerdo con la programación de oferta curricular dentro de estas franjas diarias y horarias 6:00 am-21 horas, lunes-sábado.
Ciudad: Medellín
|
|
![]() |
Titulo que otorga: Doctor en Biología
Código SNIES: 9303 Número total de créditos: 110 Duración: 8 semestres Metodología: Doctorado (investigación)
Modalidad: Presencial, mediado por TICs.
Horario: Definido de acuerdo con la programación de oferta curricular dentro de estas franjas diarias y horarias 6:00 am-21 horas, lunes-sábado.
Ciudad: Medellín
|
|
![]() |
Titulo que otorga: Doctor en Biotecnología
Código SNIES: 54787 Número total de créditos: 110 Duración: 8 semestres Metodología: Presencial, mediado por TICs.
Modalidad: Doctorado (investigación)
Horario: Definido de acuerdo con la programación de oferta curricular dentro de estas franjas diarias y horarias 6:00 am-21 horas, lunes-sábado.
Ciudad: Medellín +Ver más |
Z7_NQ5E12C0L86B60Q6EJJNRBIU95
Portal U de A - Redes Sociales - WCV(JSR 286)
Z7_NQ5E12C0L86B60Q6EJJNRBIU97